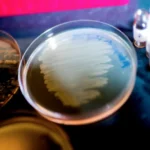
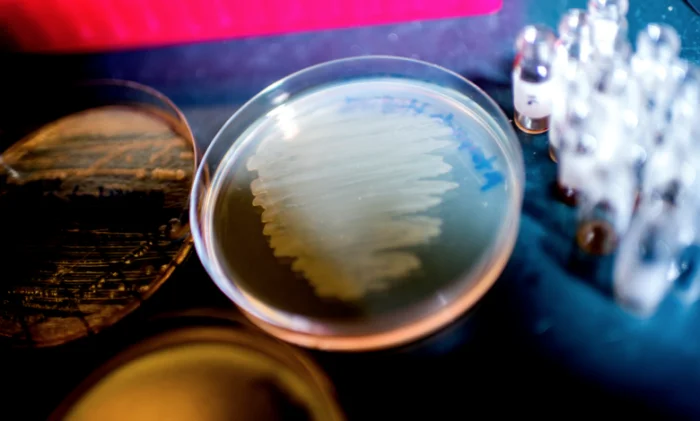
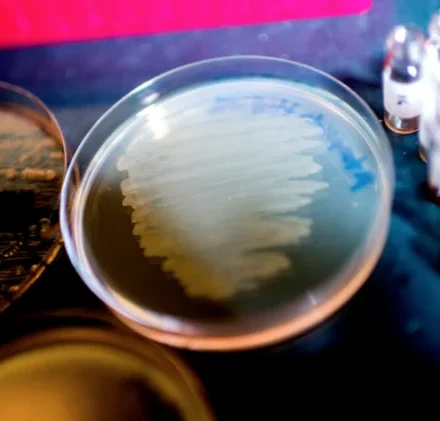

Глобальное потепление грозит Императорскому пингвину вымиранием
Исследования в океанографическом институте США (Woods Hole Oceanographic Institution - WHOI) показали, что императорские пингвины находятся под угрозой вымирания в связи с изменениями климата. По мнению авторов, эти культовые животные в полной мере…
Читать далееСуматранский носорог
Суматранские носороги являются самыми маленькими из всех видов и единственными азиатскими носорогами, обладающими двумя рогами. Их тело покрыто длинной шерстью, что свидетельствует о тесных связях с вымершими предками шерстистыми…
Читать далееЧерный носорог
Черный носорог (лат. Diceros bicornis) – один из двух видов африканского носорога. Несмотря на название, он как и белый носорог может иметь разный окрас: от темно-желтого до темно коричневого или темно…
Читать далееОрангутан
Орангутаны широко известны благодаря своему красно-коричневому меху. Они по праву считаются самыми крупными древесными млекопитающими, проводящими большую часть своей жизни на…
Читать далееТОП 10 Самых опасных растений в мире
За миллионы лет эволюции, растения разработали хитрые, а в некоторых случаях смертельные средства защиты от голодных животных. К таким охранным механизмам относятся смертельные нейротоксины, острые шипы, которые могут проколоть автомобильные шины и…
Читать далееТОП 10 Матерей в мире животных
Мама – это главное слово во всем мире. Не возможно передать ту глубину связи между мамой и ее малышом, которая возникает в момент появления на свет маленького чуда и не завершается в течении всей жизни. Нет ничего более совершенного, нежели любовь матери…
Читать далееТОП 10 Отцов в мире животных
Зачастую мама является первой, на кого возлагается долг в воспитании потомства. Но давайте все же не забывать и о роли отцов в этом нелегком деле. Самые лучшие отцы в мире животных идут на многие жертвы, когда дело касается их малышей. Они могут вести…
Читать далееТигр — описание, ареал, подвиды, питание, поведение и размножение
Численность тигров на сегодняшний день очень низка. Всего за век, было потеряно около 97% представителей вида. Их не спасает даже тот факт, что представители кошачьих являются одними из самых почитаемых животных в…
Читать далееБелый полярный медведь — описание, ареал, питание, размножение, поведение и фото
Белый медведь (Ursus maritimus) – это крупный вид медведя, населяющий ледовые поля Северного Ледовитого океана. Он считается самым крупным видом в мире (за исключением подвида бурого медведя Кадьяк, обитающего на Аляске, которые могут достигать…
Читать далееБольшая панда, или бамбуковый медведь, или гигантская панда
Большая панда – это тихое существо в характерном черно – белом костюме обожаемое во всем мире. Также панда считается национальным достоянием в Китае. Для WWF (всемирного фонда дикой природы) панда имеет особое значение, поскольку с 1961 года, момента…
Читать далееДальневосточный леопард, или амурский леопард, или амурский барс
Обычно люди думая о леопардах представляют саванны Африки. Несмотря на это, в самой северной части своего ареала, редкий подвид леопардов живет в лесах умеренного пояса на Дальнем Востоке России и севере…
Читать далее